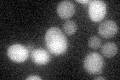
YPR172W
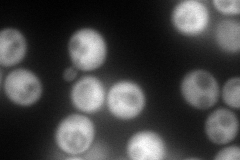
YPR172W
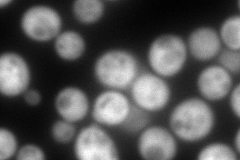
YPR172W
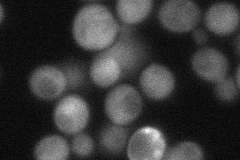
YPR172W

View description
Protein of unknown function, transcriptionally activated by Yrm1p along with genes involved in multidrug resistance
Localization:
Intensity:
Fold change:
Significance:
-
C’ GFP library in SD
cytosol25.23 -
N' NOP1pr-GFP in SD
cytosol226.16 -
N' TEF2pr-mCherry in SD
cell periphery,punctate345.288 -
N' NATIVEpr-GFP in SD
cytosol39.3798 -
N' TEF2pr-VC and Cyto-VN in SD

#N/A0 -
C’ GFP library in SD+DTT

cytosol24.450.96No -
C’ GFP library in SD+H2O2

cytosol20.810.82No -
C’ GFP library in Starvation Media

cytosol46.391.83No -
C’ GFP library on the background of Pup2-DaMP

cytosol -
C’ GFP library on the background of CCT mutant

cytosol26.45031.04788No
